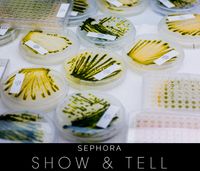
algae.jpg

Surprise! I’m not a scientist. (I know, I know, you’re shocked.) But I am a beauty junkie. And a skincare enthusiast. So I was totally excited to go behind the scenes with Tammy Yaiser, VP of Product at Algenist, to get the lowdown on their groundbreaking skincare technology and their new 10 day challenge.
 Okay, so what exactly is Alguronic Acid? What makes it so effective for anti-aging?
Okay, so what exactly is Alguronic Acid? What makes it so effective for anti-aging?
Alguronic Acid is a compound produced by microalgae that our Biotechnology scientists in San Francisco unexpectedly discovered while developing new renewable energy solutions and biofuels. Having never seen this fascinating new compound before, we began studying Alguronic Acid, and found that Alguronic Acid is the key that helps the microalgae not only to survive, but thrive, in the harshest of environmental conditions. As we further scientifically tested Alguronic Acid, we found that it has incredibly potent cell regeneration and cell protection capabilities – exactly the things we need to target and visibly correct the look of aging in our skin.
How did you discover its anti-aging properties?
How did you discover its anti-aging properties?
After the exciting discovery, our biotechnology scientists intensively researched and studied Alguronic Acid and learned that it is Alguronic Acid that is responsible for regenerating and protecting the microalgae cell. It then occurred to us that this is precisely what is needed to effectively address the signs of aging in the skin, so we began in vitro tests of Alguronic Acid in the laboratory, comparing it to other very well know anti-aging skincare ingredients. We were amazed at Alguronic Acid’s cell regeneration, elastin synthesis, melanin inhibition, and cell damage protection capabilities. This inspired us to conduct further clinical trials, which validated Alguronic Acid’s exceptional anti-aging properties, showing amazing anti-aging results in just 10 days.
 Biotechnology and Beauty? How did that happen?
Biotechnology and Beauty? How did that happen?
Totally by accident! Our biotechnology scientists literally stumbled upon Alguronic Acid while developing renewable energy and biofuels – in fact, we never intended to get into beauty or skincare! But once we discovered the benefits of Alguronic Acid, we began formulating and Algenist was born. Algenist means “The Genius of Algae.”
What is the “Algenist 10 Day Challenge”? I want in!
The 10-Day Challenge is a 10-day supply of our new Retinol Firming and Lifting Serum, packaged into 10 single-use packettes – one packette to use every day, for ten consecutive days. The 10-Day Challenge is launching for Beauty Insiders on Sephora.com later this month. It is a wonderful way of experiencing the new face of retinol – thanks to the power of Alguronic Acid.

Would you recommend using the Retinol Firming & Lifting Serum every day? Should I use it twice a day? Just in the morning? Just at night?
I recommend using the Retinol Firming & Lifting Serum every single day. If you have never used a retinol product before, begin by using the Retinol Firming and Lifting Serum once a day in the evening. Then progress to applying more frequently, up to twice per day, until you find the best routine for your skin. Note a little goes a long way, you need only one pump and always remember to use a sunscreen during the day.
At what step in my skincare regimen should I use the serum? What other Algenist products should I use it with for it to be the most effective?
Apply the Retinol Firming & Lifting Serum to dry skin, after cleansing. For even more firming and lifting, follow with our Firming and Lifting Cream, and Firming and Lifting Eye Gel – the perfect three-step regimen to boost production of skin's key structural proteins - elastin, collagen, and proteoglycans – to visibly redefine facial contours, and leave skin looking smooth, sculpted, and lifted! And always remember to use a sunscreen - the Ultra Lightweight UV Defense Fluid SPF 50 is an ultra-sheer formula that goes on smoothly for weightless daily protection against broad-spectrum UVA/UVB damage.
 Can I use both the Concentrated Reconstructing Serum & the Retinol Firming & Lifting Serum?
Can I use both the Concentrated Reconstructing Serum & the Retinol Firming & Lifting Serum?
Yes, the Concentrated Reconstructing Serum is compatible with the Retinol Firming & Lifting Serum. In the morning, apply the Concentrated Reconstructing Serum to clean, dry skin. In the evening, apply the Retinol Firming & Lifting Serum to dry skin, after cleansing. Just be sure to use a sunscreen every day.
What % of Retinol is there in the formulation?
Though we do not share the exact percentage of retinol in the formulation, the concentration of retinol in the Algenist Retinol Firming & Lifting Serum is proven to produce significant anti-aging properties. Further, the retinol ingredient in our formulation is microencapsulated and time-released for maximum benefits with no downside.
Why am I unable to open up the inside of the Retinol F&L Serum pump?
Even though we formulated the Retinol Firming & Lifting Serum with a stabilized time-released retinol, we specifically
chose an airless and airtight aluminum pump to protect the formula from light and heat. This special packaging therefore further ensures the stability of the formula to deliver the maximum effectiveness and benefits for your skin.
I heard a rumor that you make algae ice cream at your lab? True story? What does it taste like?
Yes – it is a true story. You don’t taste algae - you just taste pure A-MAZ-ING creamy, decadent deliciousness. My favorite is the chocolate – of course!

Shop Algenist> http://seph.me/155Zb9R














